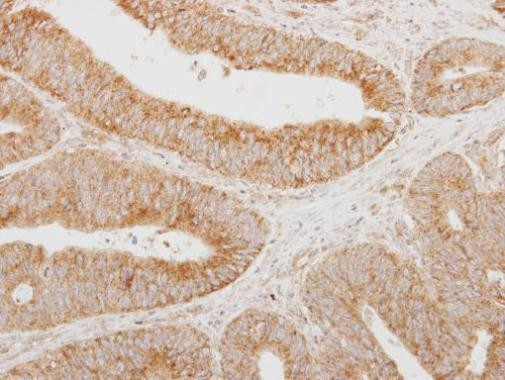
SERPINA12 Antibody in Immunohistochemistry (Paraffin) (IHC (P))

Search
Invitrogen
SERPINA12 Polyclonal Antibody
{{$productOrderCtrl.translations['antibody.pdp.commerceCard.promotion.promotions']}}
{{$productOrderCtrl.translations['antibody.pdp.commerceCard.promotion.viewpromo']}}
{{$productOrderCtrl.translations['antibody.pdp.commerceCard.promotion.promocode']}}: {{promo.promoCode}} {{promo.promoTitle}} {{promo.promoDescription}}. {{$productOrderCtrl.translations['antibody.pdp.commerceCard.promotion.learnmore']}}





Please note: We are reviewing Western blot images included in the antibody testing data in our catalog, including those provided by third parties. Unless expressly labeled or annotated as “raw-unedited”, Western blot images included in the antibody testing data in our catalog may have been edited, optimized or otherwise adjusted for presentation.
产品信息
PA5-30989
种属反应
已发表种属
宿主/亚型
分类
类型
抗原
偶联物
形式
浓度
规格
纯化类型
保存液
内含物
保存条件
运输条件
RRID
产品详细信息
Recommended positive controls: 293T, A431, Jurkat, Raji.
Store product as a concentrated solution. Centrifuge briefly prior to opening the vial.
靶标信息
Vaspin is a newly described adipocytokine expressed predominantly in visceral white adipose tissues. Structure analysis of vaspin predicts the presence of three beta-sheets, nine alpha-helices, and one central loop, which are distinctive structural features of Serpin family members. The serpins are irreversible ("suicidal") serine-protease inhibitors, characterized by having more than 30% sequence homology with alpha1-antitrypsin and a conserved tertiary structure, which contains an exposed reactive center loop that acts as a pseudo-substrate for the target proteinase. Members of this family play an important role in a number of fundamental biological processes, including blood coagulation, fibrinolysis, complement activation, angiogenesis, inflammation, and tumor suppression. In humans, the serpins represent approximately 2% of total serum proteins, of which 70% is alpha1-antitrypsin. Vaspin exhibits 40.2% sequence identity with alpha1-antitrypsin. Yet, its protease inhibitory activity is still unknown. Vaspin mRNA expression in visceral fat is positively correlated with BMI and percent of body fat. Administration of vaspin to obese mice improved glucose tolerance and insulin sensitivity, reflected by normalized blood glucose levels. It also led to the reversal of altered expression of diabetes-relevant adipocytokines, including leptin, adiponectin, resistin, and TNF-alpha. These findings suggest a potential clinical use for Vaspin in ameliorating certain aberrations seen in the diabetic/obesity metabolic syndrome.
⚠WARNING: This product can expose you to chemicals including mercury, which is known to the State of California to cause birth defects or other reproductive harm. For more information go to www.P65Warnings.ca.gov.
仅用于科研。不用于诊断过程。未经明确授权不得转售。
生物信息学
蛋白别名: a12; OL-64; Serpin A12; Vaspin; Visceral adipose tissue-derived serine protease inhibitor; Visceral adipose-specific serpin
基因别名: SERPINA12
Entrez Gene ID: (Human) 145264